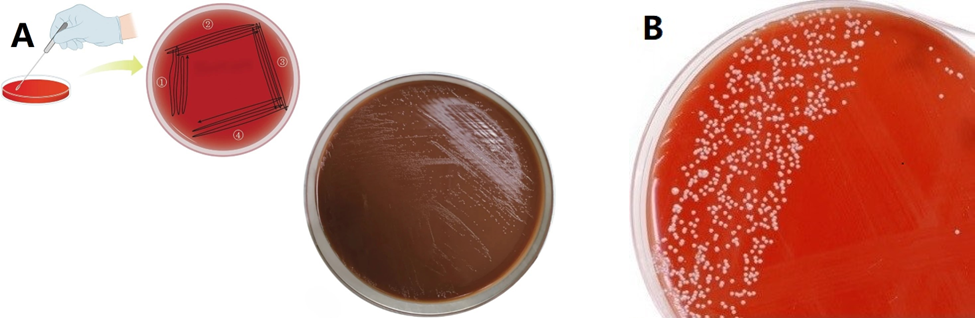

1.幽门螺杆菌(Helicobacter pylori)
物种名:幽门螺杆菌
拉丁学名:Helicobacter pylori
分类学地位:细菌界Bacteria;变形菌门Proteobacteria;
ε-变形菌纲Epsilonproteobacteria;弯曲菌目Campylobacterales;
螺杆菌科Helicobacteraceae;螺杆菌属Helicobacter
幽门螺杆菌又称幽门螺旋杆菌,是革兰氏阴性、微需氧、螺旋状的细菌(螺旋菌),通常在胃中发现[1]。幽门螺杆菌可于胃酸环境生存,它能分泌尿素酶中和胃酸,从而在胃黏膜上定植。它的螺旋形状被认为是为了穿透胃的黏液内壁从而建立感染而演化来的,可引起胃黏膜轻微的慢性发炎,或导致胃及十二指肠溃疡,且证实与多种淋巴瘤相关。70%的胃癌都和幽门螺杆菌有关,其被世界卫生组织列为一类致癌物。
1.1生物学特性
1.1.1培养特征
幽门螺杆菌为微需氧菌,最适生长条件为85%氮、10%二氧化碳、5%氧及高湿度,温度35-37°C,在<30°C或≥43°C不生长;通常3-4天可见菌落,建议培养7-10天以提高检出率。其对营养要求高,常用含血液或血清(5-10%)及蛋黄、木炭、淀粉等生长补充剂的固体培养基,如幽门螺杆菌琼脂、斯基罗琼脂、哥伦比亚血琼脂、布鲁氏菌琼脂等,并添加万古霉素、萘啶酸、两性霉素等选择性抑制剂以防污染。菌落多呈圆形、凸起、半透明或奶油色,部分培养基上伴色变或弱溶血,在不同培养基上形态可呈小型圆顶、直径约2-3 mm的红色或乳白色菌落(图1A)[2]。在尿素琼脂上,因尿素酶活性,会导致介质颜色(如从橙到粉红)变化(图2B)[3]。
图1 幽门螺杆菌的培养
1.1.2形态学特征
幽门螺杆菌是一种革兰氏阴性、微需氧的螺旋形细菌,长约2.8-5 μm、宽约0.5-0.6 μm,带有4-6条极端多鞭毛,末端钝圆,赋予其在胃黏液中强大运动能力[4]。其螺旋形态使其能“钻入”胃黏液层并定植于胃上皮细胞。面对逆境,它能转为C形、U形或球形形式,这种形态转换(包括可存活但不可培养状态)有助于长期存活与抵御不利环境。同时,它具有氧化酶、过氧化物酶和强烈尿素酶活性,增强了其对胃酸的适应性。

图2 幽门螺杆菌菌株显微照片
A:光学显微镜下照片[5],B:革兰氏染色的照片[6]
C:TEM图像[7],D:高分辨率扫描电镜下照片[8]
1.1.3生化特征
幽门螺杆菌是一种革兰阴性、微需氧、螺旋状细菌,其最显著的生化特征是尿素酶强阳性,能够快速分解尿素生成氨和二氧化碳,中和胃酸以利于在胃黏膜环境中生存;此外,该菌氧化酶和过氧化氢酶均呈阳性,有助于维持其氧化还原代谢及抵御氧化应激;同时,幽门螺杆菌具多根极性鞭毛,运动性强,可穿透胃黏液层完成定植。该菌不发酵糖类,需在低氧(约5% O₂)、高二氧化碳(约10% CO₂)条件下,于35-37℃的环境中生长,并常需富含血清或血液的选择性培养基[9]。临床上,尿素酶试验(如快速尿素酶试验、13C/14C尿素呼气试验)是其重要的快速诊断依据[10]。
1.1.4分子生物学特征
幽门螺旋杆菌的基因组中含有特殊的致病岛结构,其基因组约1.6-1.7 mb,具有高度可塑性和丰富的致病相关基因,包括cagA、vacA、babA、ureA/ureB等。通过类型IV分泌系统,CagA是其基因组上一段约40 kb的特殊基因片段,可注入胃上皮细胞并激活炎症和信号通路,VacA则可诱导细胞凋亡和免疫逃逸。其尿素酶系统产生氨以抵御胃酸,同时具备黏附素帮助长期定植[11–14]。幽门螺旋杆菌的基因多样性和频繁的基因重组使其能适应宿主免疫压力,并在宿主胃黏膜中维持长期感染,相关基因型与胃炎、溃疡及胃癌风险密切相关。
1.2分布、传播与致病性
1.2.1分布与传播
幽门螺旋杆菌是全球最常见的慢性细菌感染之一,约有一半以上人口携带,其感染率在发展中国家可达70-90%,而在发达国家仅为20-40%,多在儿童时期获得,且呈现明显的年龄、社会经济和城乡差异[15]。幽门螺杆菌主要分布在胃黏膜上皮表面的黏液层,在黏膜上皮的表面及细胞间也可见感染[16]。其主要传播途径包括家庭和人群间的口-口、粪-口及胃-口传播,不良卫生条件、受污染饮水及拥挤居住环境是重要危险因素,因此该菌的分布与传播模式与生活习惯和社会经济状况密切相关。
1.2.2致病性
幽门螺杆菌感染是全球最常见的慢性细菌感染之一,其致病过程涉及复杂的细菌-宿主相互作用。不同疾病是由幽门螺杆菌和宿主之间复杂的致病机制导致。幽门螺杆菌感染导致相关胃肠及胃肠外疾病的致病机制尚不完全清楚,目前认为可能是细菌自身形态结构、细菌毒力因子、宿主遗传和环境因素之间相互作用的结果[17]。
幽门螺旋杆菌的致病性在于其卓越的胃内定植能力及多种毒力因子的综合作用(图3)。该菌依靠尿素酶产生的氨来中和胃酸,并通过鞭毛运动穿透胃黏液层,再借助黏附素(如BabA、SabA)牢固附着于胃上皮细胞,从而实现长期生存。其最重要的毒力因子包括CagA[18]和VacA[19]:前者通过类型IV分泌系统注入宿主细胞后,干扰信号通路,促进炎症和异常增殖,增加胃癌风险;后者则诱导细胞形成空泡、损伤线粒体并抑制免疫反应,帮助细菌逃避免疫清除。同时,幽门螺旋杆菌的脂多糖和外膜蛋白能激活免疫系统,导致持续炎症反应,表现为慢性胃炎,部分患者进一步发展为消化性溃疡、萎缩性胃炎,甚至肠上皮化生与胃癌。
正因如此,世界卫生组织已将其列为Ⅰ类致癌因子,并且其感染还与胃黏膜相关淋巴组织淋巴瘤(MALT淋巴瘤)的发生密切相关[20]。总之,幽门螺旋杆菌致病性既源于细菌的生存策略,也依赖于毒力因子与宿主免疫反应之间的复杂相互作用。

图3 幽门螺杆菌感染的发病机制[21]
1.3检测方法
(1)尿素呼气试验(UBT):尿素呼气试验是目前临床最常用、被视为无创检测金标准的方法之一。其原理是利用幽门螺杆菌产生的强尿素酶活性:受检者口服13C或14C标记的尿素,如果胃内存在幽门螺杆菌,尿素会被分解为氨和标记的二氧化碳,标记CO₂经呼气排出后通过质谱或红外分析检测其比例,即可判断是否感染。该方法灵敏度和特异性均较高,常用于初筛和根除疗效随访。优点是无创、对患者依从性好;局限是检测结果会受质子泵抑制剂、抗生素、铋剂等近期用药影响,且14C属于放射性同位素(虽剂量极低),13C更安全但设备要求高、成本相对较高[22]。
(2)聚合酶链式反应(PCR):是另一类常用且灵敏的检测方法。其原理是针对幽门螺杆菌特异性基因(如16S rRNA、ureA/ureC、vacA、cagA等)设计特异性引物/探针,通过PCR扩增检测扩增产物;实时荧光qPCR还能定量菌量并识别耐药相关突变(如23S rRNA大环内酯耐药位点)。该方法适用于胃黏膜活检组织、胃液、粪便等样本,具有高灵敏度和特异性,并可提供耐药基因信息,对临床抗生素选择有价值[22]。
1.4典型案例
关于幽门螺杆菌的典型案例,虽然不像沙门氏菌、霍乱那样常见群体性急性暴发,但已有研究揭示其严重的公共卫生危害。在中国大规模家庭调查中,涉及10735个家庭共31098人,个体感染率达40.66%,家庭感染率高达71.21%,其中近20%的家庭所有成员均感染,显示幽门螺杆菌极易通过日常生活方式在家庭内部传播。此类感染虽不涉及食品或水源“超标”检测,但危害体现在高传播性和难以根除性上,处置建议以家庭为单位进行检测和治疗,避免“治一人、再传染”的循环[23,24]。此外,临床上也存在大量难治性病例,北京大学第三医院2014–2024年分析的637例患者中,采用14天铋剂四联疗法后根除率达92.3%,但副作用率高达40.3%,凸显耐药问题严重。另有个体病例显示,青少年因感染出现严重胃溃疡和出血,提示即便单例也可造成急性重症后果[25]。
从慢性长期危害角度看,幽门螺杆菌是胃癌最主要的致病因子。国际癌症研究机构(IARC)在中国的研究表明,30岁以上人群中约78.5%的非贲门胃癌和62.1%的贲门胃癌可归因于该菌感染,推算每年约34万胃癌与之相关。全球范围预测,2008–2017年出生人群未来将出现约1560万例胃癌,其中76%(约1180万例)由幽门螺杆菌引起,尤其亚洲最为严重[26]。虽然并不存在“超标”的概念,但其长期潜伏感染所带来的胃癌风险极为巨大。对此,公共卫生部门已呼吁实施“筛查-根除”政策,特别是以家庭或高危人群为单位的防控方案。由此可见,幽门螺杆菌的典型案例虽少见集中暴发,但其聚集传播与致癌负担,已构成重大公共卫生挑战。
1.5防治对策
幽门螺杆菌的防治应综合预防与治疗两方面。
预防方面,应保持健康生活方式,避免生食或未充分加热的食物,饮食规律、少吃辛辣刺激性食物,保持胃黏膜健康,同时注意个人卫生,勤洗手,尤其是餐前和如厕后,不共用餐具、筷子和牙刷,减少口-口传播;公共卫生上,需提高社区和集体环境的食品、水源卫生意识,学校和幼儿园等集体场所要注意饮食安全和用水卫生。对于有胃溃疡、慢性胃炎或家族胃癌史的人群,应定期进行幽门螺杆菌检测,包括呼气试验、血清抗体、粪便抗原或胃镜活检。
治疗方面,一旦确诊,应积极进行根除治疗,常用三联疗法[27]包括质子泵抑制剂(PPI)联合克拉霉素和阿莫西林或甲硝唑,疗程通常为10至14天;对于耐药或三联疗法失败者,可采用四联疗法[27],即PPI、铋剂及两种抗生素(如四环素、甲硝唑或阿莫西林)。治疗期间需严格遵医嘱完成全程,防止耐药产生,并在治疗后复查以确认根除。治疗期间可配合饮食调理,避免刺激性食物,根除后仍需定期随访,尤其对于胃癌高风险人群。综合来看,幽门螺杆菌防治应以健康生活方式和卫生习惯为基础,规范的药物治疗为核心,并辅以定期监测与随访,从而有效降低感染风险和相关胃病发生率。
参考文献
[1] Alfarouk KO, Bashir AHH, Aljarbou AN, et al. The possible role of helicobacter pylori in gastric cancer and its management. Frontiers in Oncology, 2019, 9: 75.
[2] Kim N, Kim J. Culture. KIM N. Helicobacter pylori. Singapore: Springer Nature, 2023: 153-160.
[3] Pokhrel P. Cultural characteristics of helicobacter pylori. Microbiology Notes, 2015.
[4] Windsor HM, ORourke J. Bacteriology and taxonomy of helicobacter pylori. Gastroenterology Clinics of North America, 2000, 29: 633-648.
[5] Krzyżek P, Franiczek R, Krzyżanowska B, et al. In vitro activity of 3-bromopyruvate, an anticancer compound, against antibiotic-susceptible and antibiotic-resistant helicobacter pylori strains. Cancers, 2019, 11: 229.
[6] Faghri J, Poursina F, Moghim S, et al. Morphological and bactericidal effects of different antibiotics on helicobacter pylori. Jundishapur Journal of Microbiology, 2014, 7: e8704.
[7] Cheng CS, Jia KF, Chen T, et al. Experimentally validated novel inhibitors of helicobacter pylori phosphopantetheine adenylyltransferase discovered by virtual high-throughput screening. PloS One, 2013, 8: e74271.
[8] Haley KP, Blanz EJ, Gaddy JA. High resolution electron microscopy of the helicobacter pylori cag type IV secretion system pili produced in varying conditions of iron availability. Journal of Visualized Experiments : JoVE, 2014: 52122.
[9] Stark RM, Greenman J, Millar MR. Physiology and biochemistry of helicobacter pylori. British Journal of Biomedical Science, 1995, 52: 282-290.
[10] 马永健, 刘国卿. 氨呼气试验用于幽门螺杆菌感染诊断的可行性. 世界华人消化杂志, 2006, 14: 3504-3508.
[11] 张建光, 段广才, 宋春花 等. 幽门螺杆菌超氧化物歧化酶基因克隆及表达. 中国公共卫生, 2010, 26: 338-340.
[12] 韩秀萍, 王芃. 幽门螺杆菌毒力致病因子研究进展. 世界华人消化杂志, 2009, 17: 2292-2297.
[13] Suerbaum S, Josenhans C. Helicobacter pylori evolution and phenotypic diversification in a changing host. Nature Reviews Microbiology, 2007, 5: 441-452.
[14] Tomb JF, White O, Kerlavage AR, et al. The complete genome sequence of the gastric pathogen helicobacter pylori. Nature, 1997, 388: 539-547.
[15] Brown LM. Helicobacter pylori: Epidemiology and routes of transmission. Epidemiologic Reviews, 2000, 22: 283-297.
[16] 金仁顺, 朴东明. 幽门螺杆菌与化生性病变在胃黏膜中的分布. 世界华人消化杂志, 2006, 14: 2030-2033.
[17] 倩高, 袁东红, 白如如 等. 幽门螺杆菌致病机制与抗体分型检测的研究. Advances in Clinical Medicine, 2024, 14: 706.
[18] 万秀坤, 刘纯杰. 幽门螺杆菌CagA蛋白及其致病机制研究进展. 中国生物工程学会第十届学术年会暨2016年全国生物技术大会论文集. 中国黑龙江哈尔滨: 132-133.
[19] Tang Z, Fu L, Liu R, et al. mechanisms of helicobacter pylori intracellular infection and reflections concerning clinical practice. Sichuan Da Xue Xue Bao, 2023, 54: 1300-1305.
[20] Gong Y, Yuan Y. Resistance mechanisms of helicobacter pylori and its dual target precise therapy. Critical Reviews in Microbiology, 2018, 44: 371-392.
[21] Conteduca V, Sansonno D, Lauletta G, et al. H. pylori infection and gastric cancer: State of the art (review). International Journal of Oncology, 2013, 42: 5-18.
[22] 李雅倩, 刘家奇, 朱晓芳 等. 幽门螺杆菌检测技术研究进展及展望. 微生物学报, 2022, 62: 1645-1655.
[23] 许雅鑫, 王启哲, 刘茹 等. 家庭管理视角下的抗幽门螺杆菌治疗1例. 中国临床案例成果数据库, 2022, 04: E03779-E03779.
[24] Zhou XZ, Lyu NH, Zhu HY, et al. Large-scale, national, family-based epidemiological study on helicobacter pylori infection in China: The time to change practice for related disease prevention. Gut, 2023, 72: 855-869.
[25] Suo BJ, Zhang YX, Li CL, et al. clinical characteristic analysis of refractory helicobacter pylori infection of 637 patients. Zhonghua Nei Ke Za Zhi, 2025, 64: 220-224.
[26] Yang L, Kartsonaki C, Yao P, et al. The relative and attributable risks of cardia and non-cardia gastric cancer associated with helicobacter pylori infection in China: A case-cohort study. The Lancet Public Health, 2021, 6: e888-e896.
[27] 中华医学会消化病学分会幽门螺杆菌学组. 2022中国幽门螺杆菌感染治疗指南. 胃肠病学, 2022, 27: 150-162.
.png)
